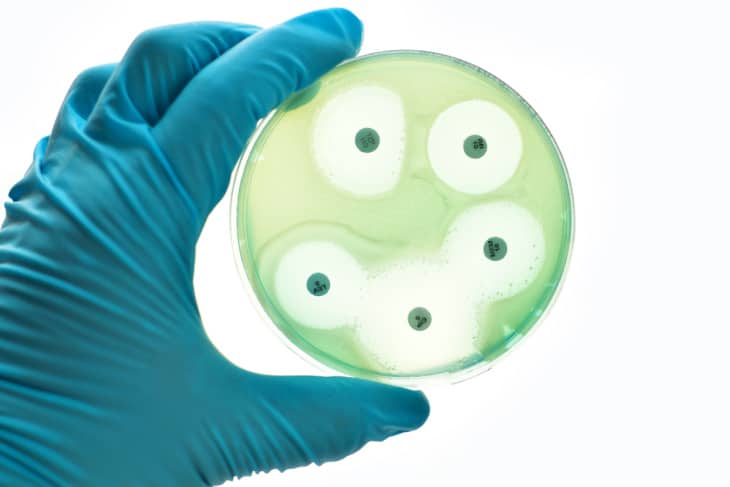
sepsis study

Blood analysis predicts sepsis and organ failure in children: University of Queensland researchers have discovered a method to predict if a child is likely to develop sepsis and go into organ failure. Associate Professor Lachlan Coin from UQ’s Institute for Molecular Bioscience said sepsis was a life-threatening condition where a severe immune response to infection […]
Read More… from Blood analysis predicts sepsis and organ failure in children